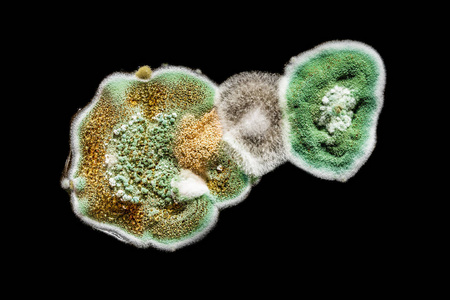
食品中真菌霉菌的发展,黑白背景下的绿色霉菌,微生物学宏观抽象背景

微生物真菌

黑色背景上绿色霉菌和真菌的纹理微生物学
图片尺寸682x1023
发霉的真菌
图片尺寸1024x1024
发展真菌霉菌在食品,绿色霉菌在白色背景,微生物宏观抽象背景
图片尺寸1200x800
绿色霉菌和真菌纹理上的黑色背景,微生物宏观抽象背景
图片尺寸1200x800
真菌
图片尺寸1080x809
环境微生物之真菌
图片尺寸1146x999
微观下的蘑菇真菌 |steve axford
图片尺寸600x450
大讲堂真菌图片小札(一)
图片尺寸999x1332
"阿莫西林"要认清,旨在5种病有效,乱用,滥用或会引火烧身
图片尺寸2100x1400
微生物学,背景,真菌,纹理,大特写
图片尺寸1200x800
写美篇真菌是一种形态多变,在自然界中扮演分解者的生物
图片尺寸1536x1536
第1节微生物在生物圈中的作用(第2课时)ppt
图片尺寸1080x810
灰指甲和手足癣的真菌长什么样
图片尺寸1080x691
临床微生物实验室真菌检测能力建设基本要求专家共识
图片尺寸654x439
微生物的神奇世界:发现隐藏的王国|细菌|真菌|植物|生物技术_网易订阅
图片尺寸660x364
裴氏着色真菌在sda上的菌落特征_食品微生物检验_食品检测技术_食品
图片尺寸500x391
帮忙看看是什么真菌啊 - 微生物 - 小木虫 - 学术 科研 互动社区
图片尺寸641x854
食品中真菌霉菌的发展,黑白背景下的绿色霉菌,微生物学宏观抽象背景
图片尺寸450x300
真菌在培养皿上的宏观黑色背景
图片尺寸1200x801
微生物镜检真菌
图片尺寸1080x1439